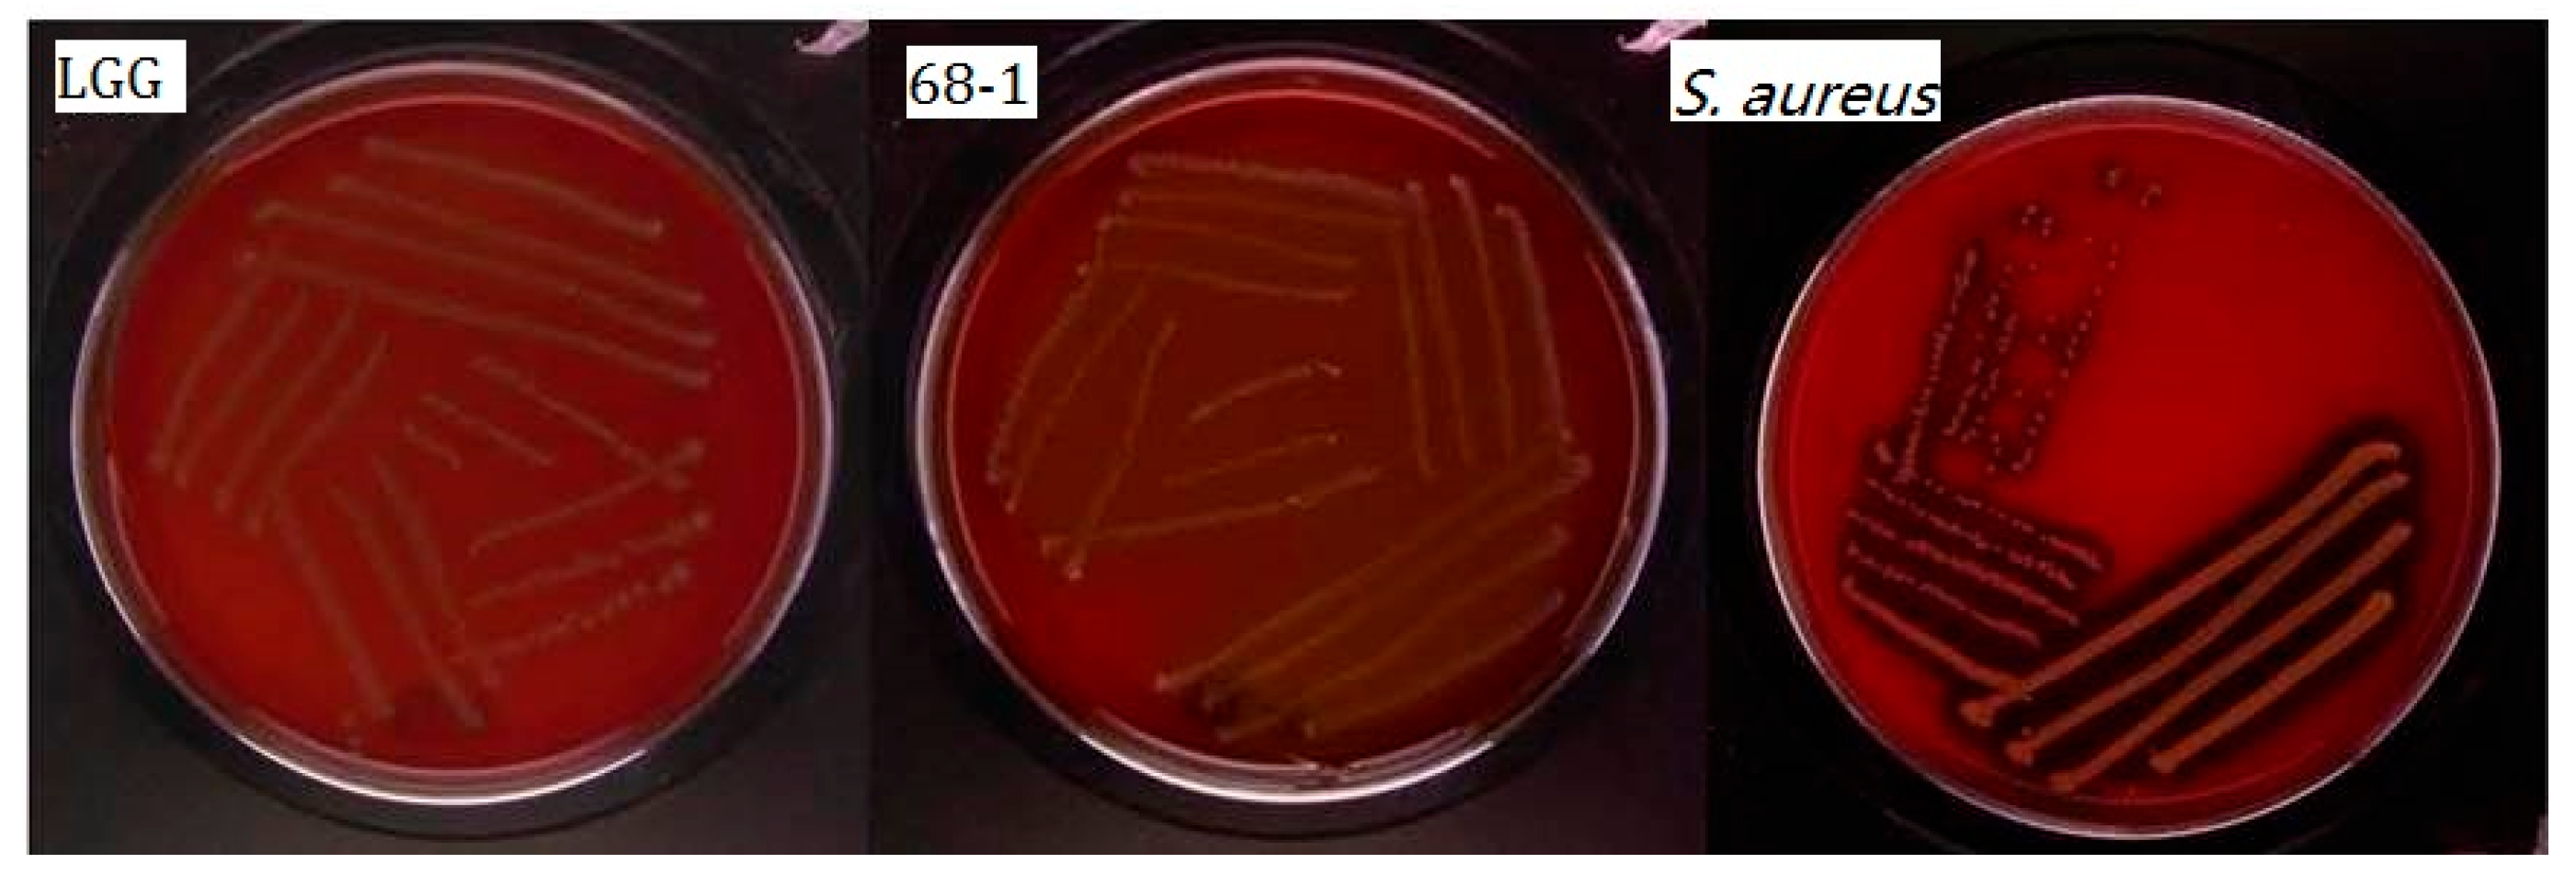

Probiotic Evaluation of Lactiplantibacillus pentosus 68-1, a Rutin Conversion Strain Isolated from Jiangshui, by Genomic Analysis and Tests In Vitro
Abstract
1. Introduction
2. Materials and Methods
2.1. Strains and Culture Conditions
2.2. Complete Genome Sequencing and Genome Assembly
2.3. Genome Annotation
2.4. Phylogenetic Analysis
2.5. Identification of Safety-Related Genes
2.6. Rutin Biotransformation by Strain 68-1
2.7. In Vitro Assessment of Probiotic Properties of Strain 68-1
2.7.1. Tolerance to Simulated Gastric Juice and Simulated Intestinal Juice
2.7.2. Cholesterol Assimilation
2.7.3. Evaluation of Adhesion and Aggregation Properties In Vitro
2.7.4. Antimicrobial Activity against Pathogens
2.8. In Vitro Safety Assessment of Strain 68-1
2.8.1. Hemolytic Activity
2.8.2. Antibiotic Resistance
2.9. Statistical Analysis
3. Results
3.1. General Genome Characteristics
3.2. Phylogenetic Analysis
3.3. Identification of Carbohydrate-Active Enzymes
3.4. Resistance to the Gastrointestinal Environment
3.5. Adhesion and Aggregation Properties
3.6. Antimicrobial Activity
3.7. Safety Assessment and Identification of Related Genes
4. Discussion
5. Conclusions
Supplementary Materials
Author Contributions
Funding
Data Availability Statement
Conflicts of Interest
References
- Zhang, J.; Wu, S.; Zhao, L.; Ma, Q.; Li, X.; Ni, M.; Zhou, T.; Zhu, H. Culture-dependent and -independent analysis of bacterial community structure in Jiangshui, a traditional Chinese fermented vegetable food. LWT-Food Sci. Technol. 2018, 96, 244–250. [Google Scholar]
- Wei, J.; Ren, W.; Wang, L.; Liu, M.; Tian, X.; Ding, G.; Ma, Z. Microbial dynamics, metabolomic profiles, and the correlation between them during fermentation of serofluid dish. J. Sci. Food Agric. 2020, 100, 5627–5636. [Google Scholar] [CrossRef]
- Li, Q.; Kang, J.; Ma, Z.; Li, X.; Liu, L.; Hu, X. Microbial succession and metabolite changes during traditional serofluid dish fermentation. LWT-Food Sci. Technol. 2017, 84, 771–779. [Google Scholar] [CrossRef]
- Son, S.-H.; Jeon, H.-L.; Jeon, E.B.; Lee, N.-K.; Park, Y.-S.; Kang, D.-K.; Paik, H.-D. Potential probiotic Lactobacillus plantarum Ln4 from kimchi: Evaluation of β-galactosidase and antioxidant activities. LWT-Food Sci. Technol. 2017, 85, 181–186. [Google Scholar] [CrossRef]
- Rao, Y.; Tao, Y.; Li, Y.; She, X.; Yang, J.; Qian, Y.; Du, H.; Liu, L.; Xiao, H. Characterization of a probiotic starter culture with anti-Candida activity for Chinese pickle fermentation. Food Funct. 2019, 10, 6936–6944. [Google Scholar] [CrossRef]
- Liu, C.; Xue, W.J.; Ding, H.; An, C.; Ma, S.J.; Liu, Y. Probiotic potential of Lactobacillus strains isolated from fermented vegetables in Shaanxi, China. Front. Microbiol. 2021, 12, 774903. [Google Scholar] [CrossRef]
- FAO/WHO. Guidelines for the Evaluation of Probiotics in Food; FAO/WHO: London, ON, Canada, 2002. [Google Scholar]
- Ramos, C.L.; Thorsen, L.; Schwan, R.F.; Jespersen, L. Strain-specific probiotics properties of Lactobacillus fermentum, Lactobacillus plantarum and Lactobacillus brevis isolates from Brazilian food products. Food Microbiol. 2013, 36, 22–29. [Google Scholar] [CrossRef] [PubMed]
- Nami, Y.; Vaseghi Bakhshayesh, R.; Mohammadzadeh Jalaly, H.; Lotfi, H.; Eslami, S.; Hejazi, M.A. Probiotic properties of Enterococcus isolated from artisanal dairy products. Front. Microbiol. 2019, 10, 300. [Google Scholar] [CrossRef] [PubMed]
- EFSA. Guidance on the characterisation of microorganisms used as feed additives or as production organisms. EFSA J. 2018, 16, e05206. [Google Scholar]
- Argyri, A.A.; Zoumpopoulou, G.; Karatzas, K.A.; Tsakalidou, E.; Nychas, G.J.; Panagou, E.Z.; Tassou, C.C. Selection of potential probiotic lactic acid bacteria from fermented olives by in vitro tests. Food Microbiol. 2013, 33, 282–291. [Google Scholar] [CrossRef]
- Oliveira, F.S.; da Silva Rodrigues, R.; de Carvalho, A.F.; Nero, L.A. Genomic analyses of Pediococcus pentosaceus ST65ACC, a bacteriocinogenic strain isolated from artisanal raw-milk cheese. Probiotics Antimicrob. 2023, 15, 630–645. [Google Scholar] [CrossRef]
- Sun, Y.; Zhang, S.; Li, H.; Zhu, J.; Liu, Z.; Hu, X.; Yi, J. Assessments of Probiotic potentials of Lactiplantibacillus plantarum strains isolated from Chinese traditional fermented food: Phenotypic and genomic analysis. Front. Microbiol. 2022, 13, 895132. [Google Scholar] [CrossRef]
- Wu, Y.-P.; Liu, D.-M.; Zhao, S.; Huang, Y.-Y.; Yu, J.-J.; Zhou, Q.-Y. Assessing the safety and probiotic characteristics of Bacillus coagulans 13002 based on complete genome and phenotype analysis. LWT-Food Sci. Technol. 2022, 155, 112847. [Google Scholar] [CrossRef]
- Riva, A.; Kolimar, D.; Spittler, A.; Wisgrill, L.; Herbold, C.W.; Abranko, L.; Berry, D. Conversion of rutin, a prevalent dietary flavonol, by the human gut microbiota. Front. Microbiol. 2020, 11, 585428. [Google Scholar] [CrossRef]
- Juca, M.M.; Cysne Filho, F.M.S.; de Almeida, J.C.; Mesquita, D.D.S.; Barriga, J.R.M.; Dias, K.C.F.; Barbosa, T.M.; Vasconcelos, L.C.; Leal, L.; Ribeiro, J.E.; et al. Flavonoids: Biological activities and therapeutic potential. Nat. Prod. Res. 2020, 34, 692–705. [Google Scholar] [CrossRef]
- Kopustinskiene, D.M.; Jakstas, V.; Savickas, A.; Bernatoniene, J. Flavonoids as anticancer agents. Nutrients 2020, 12, 457. [Google Scholar] [CrossRef]
- Pei, R.; Liu, X.; Bolling, B. Flavonoids and gut health. Curr. Opin. Biotech. 2020, 61, 153–159. [Google Scholar] [CrossRef] [PubMed]
- Goris, T.; Cuadrat, R.R.C.; Braune, A. Flavonoid-modifying capabilities of the human gut microbiome—An in silico study. Nutrients 2021, 13, 2688. [Google Scholar] [CrossRef] [PubMed]
- Amaretti, A.; Raimondi, S.; Leonardi, A.; Quartieri, A.; Rossi, M. Hydrolysis of the rutinose-conjugates flavonoids rutin and hesperidin by the gut microbiota and bifidobacteria. Nutrients 2015, 7, 2788–2800. [Google Scholar] [CrossRef] [PubMed]
- Park, C.M.; Kim, G.M.; Cha, G.S. Biotransformation of flavonoids by newly isolated and characterized Lactobacillus pentosus NGI01 strain from kimchi. Microorganisms 2021, 9, 1075. [Google Scholar] [CrossRef] [PubMed]
- Avila, M.; Jaquet, M.; Moine, D.; Requena, T.; Pelaez, C.; Arigoni, F.; Jankovic, I. Physiological and biochemical characterization of the two alpha-L-rhamnosidases of Lactobacillus plantarum NCC245. Microbiology 2009, 155, 2739–2749. [Google Scholar] [CrossRef] [PubMed]
- Lin, L.-Z.; Lu, S.; Harnly, J.M. Detection and quantification of glycosylated flavonoid malonates in celery, Chinese celery, and celery seed by LC-DAD-ESI/MS. J. Agric. Food Chem. 2007, 55, 1321–1326. [Google Scholar] [CrossRef]
- Wick, R.R.; Judd, L.M.; Gorrie, C.L.; Holt, K.E. Unicycler: Resolving bacterial genome assemblies from short and long sequencing reads. PLoS Comput. Biol. 2017, 13, e1005595. [Google Scholar] [CrossRef]
- Besemer, J.; Lomsadze, A.; Borodovsky, M. GeneMarkS: A self-trainingmethod for prediction of gene starts in microbial genomes. Implications for finding sequencemotifs in regulatory regions. Nucleic Acids Res. 2001, 29, 2607–2618. [Google Scholar] [CrossRef]
- Lowe, T.M.; Eddy, S.R. tRNAscan-SE: A program for improved detection of transfer RNA genes in genomic sequence. Nucleic Acids Res. 1997, 25, 955–964. [Google Scholar] [CrossRef] [PubMed]
- Grissa, I.; Vergnaud, G.; Pourcel, C. CRISPRFinder: A web tool to identify clustered regularly interspaced short palindromic repeats. Nucleic Acids Res. 2007, 35, W52–W57. [Google Scholar] [CrossRef] [PubMed]
- Bertelli, C.; Laird, M.R.; Williams, K.P.; Simon Fraser University Research Computing Group; Lau, B.Y.; Hoad, G.; Winsor, G.L.; Brinkman, F.S.L. IslandViewer 4: Expanded prediction of genomic islands for larger-scale datasets. Nucleic Acids Res. 2017, 45, W30–W35. [Google Scholar] [CrossRef]
- Zhou, Y.; Liang, Y.; Lynch, K.H.; Dennis, J.J.; Wishart, D.S. PHAST: A fast phage search tool. Nucleic Acids Res. 2011, 39, W347–W352. [Google Scholar] [CrossRef]
- Arndt, D.; Grant, J.R.; Marcu, A.; Sajed, T.; Pon, A.; Liang, Y.; Wishart, D.S. PHASTER: A better, faster version of the PHAST phage search tool. Nucleic Acids Res. 2016, 44, W16–W21. [Google Scholar] [CrossRef]
- Siguier, P.; Perochon, J.; Lestrade, L.; Mahillon, J.; Chandler, M. ISfinder: The reference centre for bacterial insertion sequences. Nucleic Acids Res. 2006, 34, D32–D36. [Google Scholar] [CrossRef]
- van Heel, A.J.; de Jong, A.; Song, C.; Viel, J.H.; Kok, J.; Kuipers, O.P. BAGEL4: A user-friendly web server to thoroughly mine RiPPs and bacteriocins. Nucleic Acids Res. 2018, 46, W278–W281. [Google Scholar] [CrossRef]
- Richter, M.; Rossello-Mora, R.; Oliver Glockner, F.; Peplies, J. JSpeciesWS: A web server for prokaryotic species circumscription based on pairwise genome comparison. Bioinformatics 2016, 32, 929–931. [Google Scholar] [CrossRef] [PubMed]
- Meier-Kolthoff, J.P.; Carbasse, J.S.; Peinado-Olarte, R.L.; Goker, M. TYGS and LPSN: A database tandem for fast and reliable genome-based classification and nomenclature of prokaryotes. Nucleic Acids Res. 2022, 50, D801–D807. [Google Scholar] [CrossRef]
- Chen, L.; Zheng, D.; Liu, B.; Yang, J.; Jin, Q. VFDB 2016: Hierarchical and refined dataset for big data analysis—10 years on. Nucleic Acids Res. 2016, 44, D694–D697. [Google Scholar] [CrossRef] [PubMed]
- Cosentino, S.; Larsen, M.V.; Aarestrup, F.M.; Lund, O. PathogenFinder-distinguishing friend from foe using bacterial whole genome sequence data. PLoS ONE 2013, 8, e77302. [Google Scholar] [CrossRef]
- Alcock, B.P.; Raphenya, A.R.; Lau, T.T.Y.; Tsang, K.K.; Bouchard, M.; Edalatmand, A.; Huynh, W.; Nguyen, A.V.; Cheng, A.A.; Liu, S.; et al. CARD 2020: Antibiotic resistome surveillance with the comprehensive antibiotic resistance database. Nucleic Acids Res. 2020, 48, D517–D525. [Google Scholar] [CrossRef] [PubMed]
- Moriya, Y.; Itoh, M.; Okuda, S.; Yoshizawa, A.C.; Kanehisa, M. KAAS: An automatic genome annotation and pathway reconstruction server. Nucleic Acids Res. 2007, 35, W182–W185. [Google Scholar] [CrossRef]
- Quattrini, M.; Korcari, D.; Ricci, G.; Fortina, M.G. A polyphasic approach to characterize Weissella cibaria and Weissella confusa strains. J. Appl. Microbiol. 2020, 128, 500–512. [Google Scholar] [CrossRef]
- Michlmayr, H.; Kneifel, W. Beta-Glucosidase activities of lactic acid bacteria: Mechanisms, impact on fermented food and human health. FEMS Microbiol. Lett. 2014, 352, 1–10. [Google Scholar] [CrossRef]
- Beekwilder, J.; Marcozzi, D.; Vecchi, S.; de Vos, R.; Janssen, P.; Francke, C.; van Hylckama Vlieg, J.; Hall, R.D. Characterization of rhamnosidases from Lactobacillus plantarum and Lactobacillus acidophilus. Appl. Environ. Microbiol. 2009, 75, 3447–3454. [Google Scholar] [CrossRef]
- Chokesajjawatee, N.; Santiyanont, P.; Chantarasakha, K.; Kocharin, K.; Thammarongtham, C.; Lertampaiporn, S.; Vorapreeda, T.; Srisuk, T.; Wongsurawat, T.; Jenjaroenpun, P.; et al. Safety assessment of a Nham starter culture Lactobacillus plantarum BCC9546 via whole-genome analysis. Sci. Rep. 2020, 10, 10241. [Google Scholar] [CrossRef]
- Partridge, S.R.; Kwong, S.M.; Firth, N.; Jensen, S.O. Mobile genetic elements associated with antimicrobial resistance. Clin. Microbiol. Rev. 2018, 31, e00088-17. [Google Scholar] [CrossRef] [PubMed]
- Shin, N.R.; Moon, J.S.; Shin, S.Y.; Li, L.; Lee, Y.B.; Kim, T.J.; Han, N.S. Isolation and characterization of human intestinal Enterococcus avium EFEL009 converting rutin to quercetin. Lett. Appl. Microbiol. 2016, 62, 68–74. [Google Scholar] [CrossRef]
- Liu, D.; Huang, Y.; Liang, M. Analysis of the probiotic characteristics and adaptability of Lactiplantibacillus plantarum DMDL 9010 to gastrointestinal environment by complete genome sequencing and corresponding phenotypes. LWT-Food Sci. Technol. 2022, 158, 113129. [Google Scholar] [CrossRef]
- Jia, F.F.; Zhang, L.J.; Pang, X.H.; Gu, X.X.; Abdelazez, A.; Liang, Y.; Sun, S.R.; Meng, X.C. Complete genome sequence of bacteriocin-producing Lactobacillus plantarum KLDS1.0391, a probiotic strain with gastrointestinal tract resistance and adhesion to the intestinal epithelial cells. Genomics 2017, 109, 432–437. [Google Scholar] [CrossRef]
- Soni, R.; Keharia, H.; Dunlap, C.; Pandit, N.; Doshi, J. Functional annotation unravels probiotic properties of a poultry isolate, Bacillus velezensis CGS1.1. LWT-Food Sci. Technol. 2022, 153, 112471. [Google Scholar] [CrossRef]
- Abriouel, H.; Perez Montoro, B.; Casimiro-Soriguer, C.S.; Perez Pulido, A.J.; Knapp, C.W.; Caballero Gomez, N.; Castillo-Gutierrez, S.; Estudillo-Martinez, M.D.; Galvez, A.; Benomar, N. Insight into potential probiotic markers predicted in Lactobacillus pentosus MP-10 genome sequence. Front. Microbiol. 2017, 8, 891. [Google Scholar] [CrossRef]
- Wei, C.; Luo, K.; Wang, M.; Li, Y.; Pan, M.; Xie, Y.; Qin, G.; Liu, Y.; Li, L.; Liu, Q.; et al. Evaluation of potential probiotic properties of a strain of Lactobacillus plantarum for shrimp farming: From beneficial functions to safety assessment. Front. Microbiol. 2022, 13, 854131. [Google Scholar] [CrossRef]
- Stergiou, O.S.; Tegopoulos, K.; Kiousi, D.E.; Tsifintaris, M.; Papageorgiou, A.C.; Tassou, C.C.; Chorianopoulos, N.; Kolovos, P.; Galanis, A. Whole-genome sequencing, phylogenetic and genomic analysis of Lactiplantibacillus pentosus L33, a potential probiotic strain isolated from fermented sausages. Front. Microbiol. 2021, 12, 746659. [Google Scholar] [CrossRef]
- Ye, K.; Li, P.; Gu, Q. Complete genome sequence analysis of a strain Lactobacillus pentosus ZFM94 and its probiotic characteristics. Genomics 2020, 112, 3142–3149. [Google Scholar] [CrossRef]
- Syrokou, M.K.; Paramithiotis, S.; Drosinos, E.H.; Bosnea, L.; Mataragas, M. A comparative genomic and safety assessment of six Lactiplantibacillus plantarum subsp. argentoratensis strains isolated from spontaneously fermented Greek wheat sourdoughs for potential biotechnological application. Int. J. Mol. Sci. 2022, 23, 2487. [Google Scholar] [CrossRef] [PubMed]
- Campedelli, I.; Mathur, H.; Salvetti, E.; Clarke, S.; Rea, M.C.; Torriani, S.; Ross, R.P.; Hill, C.; O’Toole, P.W. Genus-wide assessment of antibiotic resistance in Lactobacillus spp. Appl. Environ. Microbiol. 2019, 85, e01738-18. [Google Scholar] [CrossRef] [PubMed]
- Das, D.J.; Shankar, A.; Johnson, J.B.; Thomas, S. Critical insights into antibiotic resistance transferability in probiotic Lactobacillus. Nutrition 2020, 69, 110567. [Google Scholar] [CrossRef] [PubMed]

| Feature | Chromosome | Plasmid 1 | Plasmid 2 | Plasmid 3 | Plasmid 4 | Plasmid 5 | All |
|---|---|---|---|---|---|---|---|
| Size (bp) | 3,482,151 | 8862 | 48,711 | 37,700 | 4319 | 2009 | 3,583,752 |
| GC content (%) | 46.53 | 36.54 | 39.71 | 41.93 | 39.85 | 37.98 | 46.32 |
| Number of ORF | 3114 | 12 | 49 | 38 | 6 | 1 | 3220 |
| tRNA genes | 64 | 0 | 0 | 0 | 0 | 0 | 64 |
| rRNA genes | 16 | 0 | 0 | 0 | 0 | 0 | 16 |
| Size (bp) | 3,482,151 | 8862 | 48,711 | 37,700 | 4319 | 2009 | 3,583,752 |
| Category | Indicator Strain | LGG | 068-1 |
|---|---|---|---|
| Indicator bacteria 1 | Listeria monocytogenes CICC21635 | ++ | ++ |
| Enterococcus faecalis CICC10396 | + | ++ | |
| Enterococcus faecium CGMCC1.101 | ++ | + | |
| Escherichia coli CMCC44102 | ++ | +++ | |
| Salmonella paratyphi B CMCC50094 | - | +++ | |
| Shigella flexneri CMCC51574 | ++ | +++ | |
| Staphylococcus aureus CGMCC1.0089 | +++ | +++ | |
| Indicator fungi 2 | Rhizoctonia solani CICC40529 | - | + |
| Candida albicans GGMCC2.2086 | - | + | |
| Aspergillus flavus CICC10375 | - | + | |
| Fusarium oxysporum CICC2532 | + | + |
| Antibiotics | MIC (μg/mL) | |
|---|---|---|
| EFSA Breakpoints 1 | Test Values 2 | |
| Ampicillin | 2 | 16 (R) |
| Gentamicin | 16 | 128 (R) |
| Kanamycin | 64 | 1024(R) |
| Erythromycin | 1 | <1 (S) |
| Clindamycin | 4 | <2 (S) |
| Tetracycline | 32 | 8 (S) |
| Chloramphenicol | 8 | 4 (S) |
Disclaimer/Publisher’s Note: The statements, opinions and data contained in all publications are solely those of the individual author(s) and contributor(s) and not of MDPI and/or the editor(s). MDPI and/or the editor(s) disclaim responsibility for any injury to people or property resulting from any ideas, methods, instructions or products referred to in the content. |
© 2024 by the authors. Licensee MDPI, Basel, Switzerland. This article is an open access article distributed under the terms and conditions of the Creative Commons Attribution (CC BY) license (https://creativecommons.org/licenses/by/4.0/).
Share and Cite
Xue, W.; Liu, C.; Liu, Y.; Ding, H.; An, C.; Zhang, S.; Ma, S.; Zhang, Q. Probiotic Evaluation of Lactiplantibacillus pentosus 68-1, a Rutin Conversion Strain Isolated from Jiangshui, by Genomic Analysis and Tests In Vitro. Fermentation 2024, 10, 87. https://doi.org/10.3390/fermentation10020087
Xue W, Liu C, Liu Y, Ding H, An C, Zhang S, Ma S, Zhang Q. Probiotic Evaluation of Lactiplantibacillus pentosus 68-1, a Rutin Conversion Strain Isolated from Jiangshui, by Genomic Analysis and Tests In Vitro. Fermentation. 2024; 10(2):87. https://doi.org/10.3390/fermentation10020087
Chicago/Turabian StyleXue, Wenjiao, Chen Liu, Yao Liu, Hao Ding, Chao An, Shizhe Zhang, Saijian Ma, and Qiwen Zhang. 2024. "Probiotic Evaluation of Lactiplantibacillus pentosus 68-1, a Rutin Conversion Strain Isolated from Jiangshui, by Genomic Analysis and Tests In Vitro" Fermentation 10, no. 2: 87. https://doi.org/10.3390/fermentation10020087
APA StyleXue, W., Liu, C., Liu, Y., Ding, H., An, C., Zhang, S., Ma, S., & Zhang, Q. (2024). Probiotic Evaluation of Lactiplantibacillus pentosus 68-1, a Rutin Conversion Strain Isolated from Jiangshui, by Genomic Analysis and Tests In Vitro. Fermentation, 10(2), 87. https://doi.org/10.3390/fermentation10020087
